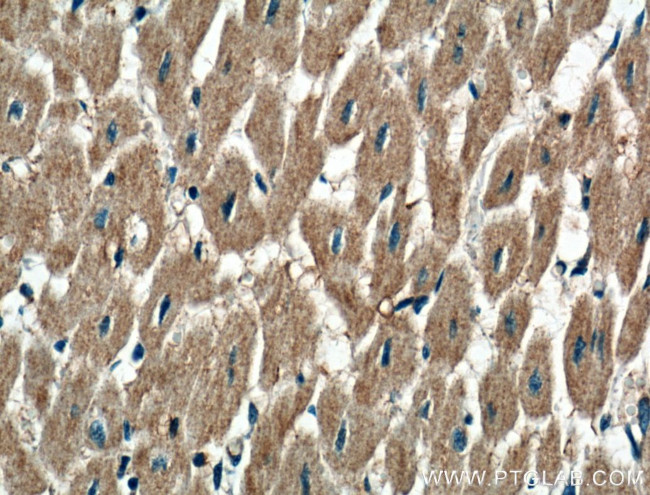
P2RX3 Antibody in Immunohistochemistry (Paraffin) (IHC (P))

Search
Proteintech
P2RX3 Polyclonal Antibody
{{$productOrderCtrl.translations['antibody.pdp.commerceCard.promotion.promotions']}}
{{$productOrderCtrl.translations['antibody.pdp.commerceCard.promotion.viewpromo']}}
{{$productOrderCtrl.translations['antibody.pdp.commerceCard.promotion.promocode']}}: {{promo.promoCode}} {{promo.promoTitle}} {{promo.promoDescription}}. {{$productOrderCtrl.translations['antibody.pdp.commerceCard.promotion.learnmore']}}
产品信息
17843-1-AP
种属反应
宿主/亚型
分类
类型
抗原
偶联物
形式
浓度
规格
纯化类型
保存液
内含物
保存条件
运输条件
产品详细信息
Immunogen sequence: LHEKAYQVR DTAIESSVVT KVKGSGLYAN RVMDVSDYVT PPQGTSVFVI ITKMIVTENQ MQGFCPESEE KYRCVSDSQC GPERLPGGGI LTGRCVNYSS VLRTCEIQGW CPTEVDTVET PIMMEAENFT IFIKNSIRFP LFNFEKGNLL PNLTARDMKT CRFHPDKDPF CPILRVGDVV KFAGQDFAKL ARTGGVLGIK IGWVCDLDKA WDQCIPKYSF TRLDSVSEKS SVSPGYNFRF AKYYKMENGS EYRTLLKAFG IRFDVLVYGN AGKFNIIPTI ISSV (44-326 aa encoded by BC074792)
靶标信息
The product of this gene belongs to the family of purinoceptors for ATP. This receptor functions as a ligand-gated ion channel and may transduce ATP-evoked nociceptor activation. Mouse studies suggest that this receptor is important for peripheral pain responses, and also participates in pathways controlling urinary bladder volume reflexes. It is possible that the development of selective antagonists for this receptor may have a therapeutic potential in pain relief and in the treatment of disorders of urine storage.
仅用于科研。不用于诊断过程。未经明确授权不得转售。
生物信息学
蛋白别名: ATP receptor; MGC129956; P2X purinoceptor 3; p2X receptor 3; P2X receptor, subunit 3; P2X3; p2X3 purinoceptor; p2xr3; Purinergic receptor; purinergic receptor P2X, ligand gated ion channel, 3; purinergic receptor P2X3; purinoceptor P2X3
基因别名: 4930513E20Rik; P2RX3; P2X3
UniProt ID: (Human) P56373, (Rat) P49654, (Mouse) Q3UR32
Entrez Gene ID: (Human) 5024, (Rat) 81739, (Mouse) 228139